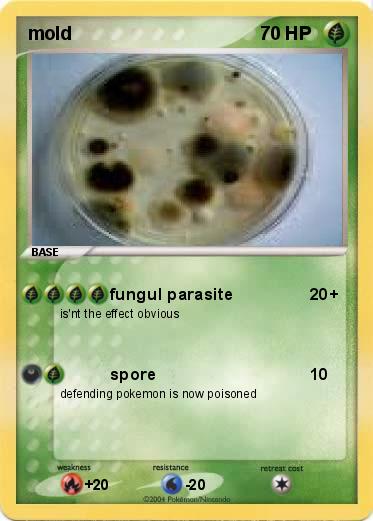
Pokemon mold

Pokemon mold
My card
Pokemon Passport
Creation Date : 26 July 2010
Name : mold
Type : Grass
Attack 1 : fungul parasite
is'nt the effect obvious
Attack 2 : spore
defending pokemon is now poisoned
Related cards









MyPokeCard.com is a funny site to design your own pokemon card, vote for the best pokemon cards and create pokemon colorings